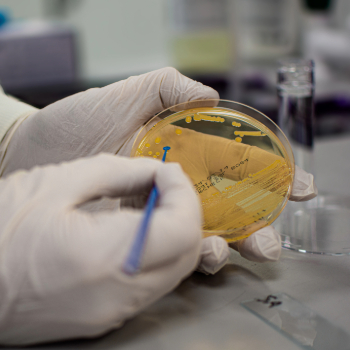
BACTERIAL IDENTIFICATION

STERIS labs annual review
January 8, 2019
2018 was another exciting year for STERIS Laboratories as we expanded both in locations and global service offerings.
Early in the year, we opened our second U.S. facility in Libertyville, Illinois.
The location of this laboratory is on the same campus as the Radiation Technology Center with the Radiation TechTeam®, and offers Customers a unique, comprehensive offering to support their ISO11137 validations.
STERIS Laboratories continues to invest in systems and equipment to improve our overall service offering.
2018 saw the implementation of the new laboratory information management system (LIMS) in Utrecht, Netherlands, with other labs coming on line during 2019.
The LIMS system is being deployed to improve the Customer experience with faster reporting and better tracking visibility, to ensure continued compliance, and to improve internal efficiencies.
The MALDI-ToF Identification system added a few years ago in Tullamore, Ireland, continues to see significant demand for identification testing of microorganisms, and we have now added a second identical system in Brooklyn Park, Minnesota.
We have announced recently that 2019 will bring the opening of a new Laboratory in Tullamore, Ireland, offering increased capacity and modernized testing facilities for our Irish Customer base
Finally, we are very pleased to expand our service offering through the addition of analytical packaging and product validation services and support in our newly acquired Galway, Ireland facility. We are excited to offer these specialized and very critical services to our STERIS Laboratories Customer base worldwide.
The global STERIS Laboratories team would like to thank our Customers for your business in 2018. We look forward to continuing our partnership through 2019 and beyond.
Mark Botting
Director, STERIS Laboratories
About STERIS
STERIS is a leading global provider of products and services that support patient care with an emphasis on infection prevention.
WE HELP OUR CUSTOMERS CREATE A HEALTHIER AND SAFER WORLD by providing innovative healthcare and life sciences products and services.
For more information, visit www.steris.com.





